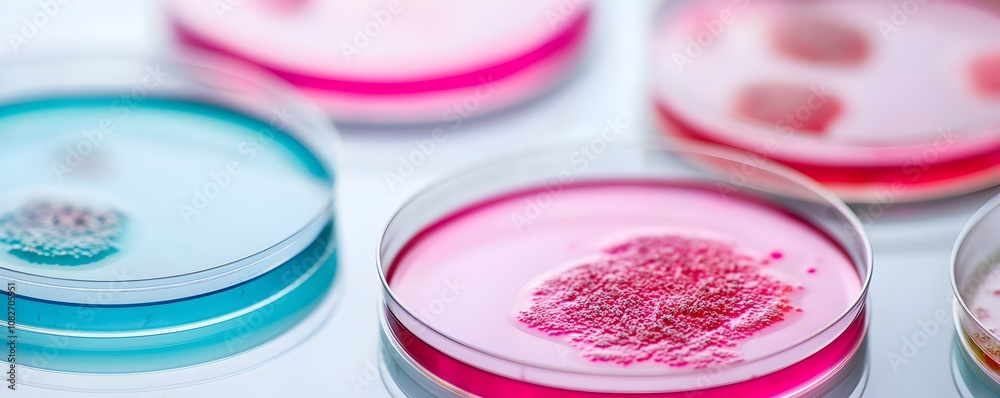
Naklejka premium Vibrant Microbial Cultures in Petri Dishes - Macro View of Intricate Textures and Unique Growth Patterns Under Soft Diffused Lighting

RABAT DO 40% - wygasa 15.12 !!! | Darmowa dostawa od 290zł | Potrzebujesz pomocy? Zadzwoń 22 678 07 67
Jakiego obrazu szukasz?
Użyj wyszukiwarki i szukaj wśród milionów zdjęć.
Naklejka premium Vibrant Microbial Cultures in Petri Dishes - Macro View of Intricate Textures...

- Zalaminowana,
całkowicie zmywalna - Łatwy montaż
bez bąbli - Odporna na wilgoć
- Bezpieczna, atestowana
w PZH i ITB
Naklejka PREMIUM zalaminowana
Główne cechy:
• wysyłka od 390 zł gratis • jakość PREMIUM • atest PZH • kolory utrzymują wybarwienie przez ponad 10 lat • łatwość montażu bez bąbli • swoboda przy wielokrotnym myciu i szorowaniu • odporna na wilgoć • maksymalna szerokość jednego brytu 123 cm • Eco Friendly - pracujemy na produktach przyjaznych środowisku
Zastosowanie:
• drzwi, meble, okna, szklane ściany, lodówka • naklejka posiada atest higieniczny PZH oraz atest trudnopalności Instytutu Techniki Budowlanej
.:: Ważna wskazówka ::.
Naklejka przeznaczona jest do montażu tylko na podłożach niewsiąkliwych, czyli na meblach, drzwiach metalowych lub drewnianych, szkle itp.
Jeśli planujesz zamontować wybraną grafikę np. na wytynkowanych ścianach - czyli na podłożu wsiąkliwym - wybierz FOTOTAPETĘ PREMIUM.
DLACZEGO MY:
- BEZPIECZNE
ZAKUPY - SZYBKA
DOSTAWA - KLEJ
GRATIS - PRODUKT
LAMINOWANY - LAT
NA RYNKU

